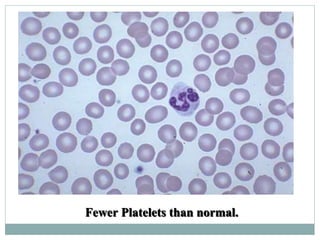
Fewer Platelets than normal.

This document discusses bleeding disorders in children, focusing on immune thrombocytopenic purpura (ITP). ITP is characterized by thrombocytopenia caused by autoantibodies against platelets. It most commonly presents as bruising and bleeding in otherwise healthy 1-4 year olds after a viral infection. Diagnosis is based on low platelet count and the absence of other causes. Most cases resolve spontaneously within 3-6 months without treatment.